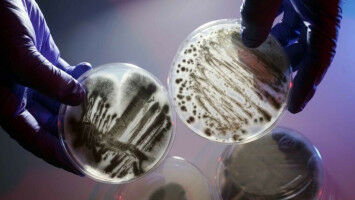
A way out of the antibiotics crisis

science wire
Pharmacology
Results 451 - 500 of 4240.
Health - Pharmacology - 09.12.2024

Brussels, December 9, 2024 - Therapeutic mRNAs offer great potential as a versatile and precise tool against cancer and various other diseases.
Health - Pharmacology - 06.12.2024
Duncan Richards appointed as Head of Department of Medicine
Pharmacology - Health - 05.12.2024
First in human study for Huntington’s disease led by UCL academic
Pharmacology - Innovation - 04.12.2024
Imperial spinout Siftr Bio aims to improve precision of ADC cancer drugs
Health - Pharmacology - 03.12.2024
Decontaminating the arms of oncology chairs to protect patients and healthcare workers
A recent study confirmed the effectiveness of six different methods for removing cytotoxic drugs from the arms of chairs in outpatient oncology clinics.
Pharmacology - Health - 03.12.2024

The new balloon can be expanded before a meal to prevent overeating, then deflated when no longer needed.
Health - Pharmacology - 02.12.2024
Tracking down and eliminating HIV dormant in the body: a major step forward
A research team is working to develop a method to reactivate latent HIV in virus carriers in order to eliminate it from the body permanently.
Health - Pharmacology - 29.11.2024

A new chimeric antigen receptor T cell (CAR-T) therapy has delivered promising results in treating patients with an aggressive blood cancer, in results from a clinical trial led by researchers at UCL and UCLH.
Pharmacology - Health - 29.11.2024
Life-changing cream to treat skin cancer moves closer to reality
Pharmacology - Life Sciences - 28.11.2024
Biodiversity as a source of innovative drug candidates
Can small protein molecules from plants, insects, cone snails or snakes serve as blueprints for active substances with reduced side effects' This is the question that the international consortium "Bi
Health - Pharmacology - 28.11.2024

Pharmacology - Health - 27.11.2024
Greater patient education needed around antidepressants which may reduce genital sensitivity, SFU study finds
The use of antidepressants is associated with sexual side effects including reduced genital sensitivity that persists after stopping the medication, a new Simon Fraser University study finds.
Health - Pharmacology - 27.11.2024

Ready to live: 40 years of HIV and AIDS leadership at Johns Hopkins As World AIDS Day nears, looking back at a devastating disease and forward to a brighter future Joel Blankson has been treating pat
Health - Pharmacology - 27.11.2024
Creating innovative health solutions for individuals and populations
Life Sciences - Pharmacology - 26.11.2024
New imaging of bacterial DNA uncovers secrets to future antibiotic design
In a new study, scientists from our top-rated Biosciences department joined forces with researchers from Jagiellonian University (Poland), and the John Innes Centre to reveal how a bacterial enzyme called DNA gyrase twists and stabilises DNA.
Health - Pharmacology - 26.11.2024

Pharmacology - Chemistry - 26.11.2024

Working alongside ANU scientists, we detected a recreational sedative - methylmethaqualone - circulating in Canberra for the first time.
Health - Pharmacology - 25.11.2024
New therapy from UI Health offers FDA-approved treatment option for brittle type 1 diabetes
Health - Pharmacology - 21.11.2024

Health - Pharmacology - 21.11.2024

Health - Pharmacology - 20.11.2024
Health - Pharmacology - 20.11.2024

Pharmacology - Health - 17.11.2024

Understanding how cancer cells grow and change could be the key to disrupting how they proliferate. Dr Griselda Awanis is using a new tracking technology to understand just this.
Pharmacology - Career - 14.11.2024
Pharmacy technicians undervalued and underpaid, reveals study
Many of England's pharmacy technicians are forced to endure low pay, poor job satisfaction, bullying, lack of support and stressful work environments, a study by University of Manchester researchers has shown.
Health - Pharmacology - 14.11.2024
New therapeutic approach for severe COVID-19
An international research consortium, with significant participation from MedUni Vienna, has tested a novel therapeutic concept to treat virus-induced lung failure in patients with severe COVID-19 in a phase 2 clinical trial.
Health - Pharmacology - 14.11.2024

Health - Pharmacology - 14.11.2024

Health - Pharmacology - 13.11.2024
Diabetes rate doubles to 800 million adults, but over half are untreated
The total number of adults living with type 1 or type 2 diabetes in the world has surpassed 800 million, according to new Imperial-led research. The authors say there is an urgent need to improve early detection and effective treatment of diabetes in lowand middle-income countries (LMICs), where cases have drastically increased since 1990.
Health - Pharmacology - 13.11.2024
University of Glasgow scientists awarded £1.5m to find better and kinder cancer treatments
Health - Pharmacology - 12.11.2024
UCL spinout Autolus gains US approval for cancer therapy
Autolus Therapeutics, a UCL spinout company, has received U.S. Food and Drug Administration (FDA) approval, for a next-generation CAR-T cell therapy, developed to treat adults with an aggressive blood cancer.
Health - Pharmacology - 12.11.2024
Schulich student researcher targets treatments for life-threatening lung condition
Health - Pharmacology - 11.11.2024

Health - Pharmacology - 08.11.2024

Health - Pharmacology - 07.11.2024
New research seeks to better understand the role of the gut microbiome in Crohn’s disease
Researchers at the University of Glasgow have secured more than $3m to study the role the gut microbiome plays in post-operative outcomes for patients with Crohn's disease.
Health - Pharmacology - 07.11.2024

Pharmacology - Innovation - 06.11.2024

The working group headed by Denise Steiner and based at the PharmaCampus is looking for new ways to get active ingredients into the body Her first steps on a long working day often lead Lena Mahlberg to the precision scales in Room 155, a lab in C Building on the PharmaCampus.
Life Sciences - Pharmacology - 05.11.2024

Health - Pharmacology - 05.11.2024
New criteria to avoid the over-diagnosis of Alzheimer’s Disease
A global expert panel led by HUG, UNIGE and the Salpêtrière Hospital advocate that clinical signs as well as biomarkers must be taken into account.
Health - Pharmacology - 04.11.2024

Health - Pharmacology - 01.11.2024
New early phase trial for patients with recurrent glioblastoma
Health - Pharmacology - 01.11.2024
Study on opioid poisoning in children points to prevention strategies
Most fatal pediatric opioid poisonings among children occur in their home with many following a history of maltreatment, a new Yale study finds. At least a quarter of children in the United States who died from opioid poisoning between 2004 and 2020 were victims of prior abuse or neglect, a new Yale study finds, and over two-thirds of 10- to 17-year-olds who suffered fatal poisonings had a history of substance use.
Pharmacology - Environment - 29.10.2024

Bonn researchers show which procedure reduces the waste of the anesthetic Propofol is used in the operating room to induce anesthesia. In order to maintain anesthesia, total intravenous anesthesia is usually followed by a continuous infusion of the drug via a separate syringe pump. This is not entirely sustainable: propofol produces around 45 percent of the drug waste in the operating room and a quarter of the drug remains unused.
Pharmacology - Health - 29.10.2024
University secures beLAB1407 funding for new heart drug
Health - Pharmacology - 29.10.2024

Pharmacology - Health - 29.10.2024
Helping patients to manage chronic pain without strong opioids - a real possibility
Our researchers are changing lives by equipping clinicians and patients with the skills to help manage painful health conditions without using potentially harmful strong opioids. Experts from our Wolfson Research Institute for Health and Wellbeing have developed a ten-footsteps training programme with the Live Well with Pain team.
Health - Pharmacology - 28.10.2024

The combination of phototherapy and chemotherapy could offer a more effective way to fight aggressive tumors. Patients with late-stage cancer often have to endure multiple rounds of different types of treatment, which can cause unwanted side effects and may not always help. In hopes of expanding the treatment options for those patients, MIT researchers have designed tiny particles that can be implanted at a tumor site, where they deliver two types of therapy: heat and chemotherapy.
Health - Pharmacology - 25.10.2024

Health - Pharmacology - 24.10.2024
AI model can predict health risks, including early death, from ECGs
A new AI model can predict patients' risk of developing and worsening disease, and even their risk of early death, using an electrocardiogram (ECG). Researchers at Imperial College London and Imperial College Healthcare NHS Trust believe their work, published today in Lancet Digital Health, could be used in the NHS within five years.
Health - Pharmacology - 23.10.2024

Health - Pharmacology - 21.10.2024
A look at infectious diseases in Ticino
How widespread are infectious diseases in Ticino today? Enos Bernasconi, professor at the Faculty of Biomedicine of the Università della Svizzera italiana (USI) and deputy head physician at Ente Ospe
Health - Today
Cortical thickness, schizophrenia, and causality in psychiatry: when the trace is mistaken for the cause
Cortical thickness, schizophrenia, and causality in psychiatry: when the trace is mistaken for the cause
Career - Today
Low-income students and girls are steered away from 'risky' creative careers at school
Low-income students and girls are steered away from 'risky' creative careers at school

Environment - Today
UCalgary expedition, with NASA, Canadian and European space agencies, sets out to better understand state of Arctic ice
UCalgary expedition, with NASA, Canadian and European space agencies, sets out to better understand state of Arctic ice

Social Sciences - Mar 24
Young people's wellbeing is improving in Greater Manchester, major survey finds
Young people's wellbeing is improving in Greater Manchester, major survey finds
Environment - Mar 24
Australia's environment is improving but climate change is 'accelerating' damage to ecosystems and wildlife
Australia's environment is improving but climate change is 'accelerating' damage to ecosystems and wildlife

Psychology - Mar 23
The grief myth: it doesn't come in stages or follow a checklist - like love, it endures
The grief myth: it doesn't come in stages or follow a checklist - like love, it endures
History & Archeology - Mar 23
The UV has played a part in the discovery of a 3,500-year-old loom that sheds light on key aspects of the Bronze Age textile revolution
The UV has played a part in the discovery of a 3,500-year-old loom that sheds light on key aspects of the Bronze Age textile revolution













